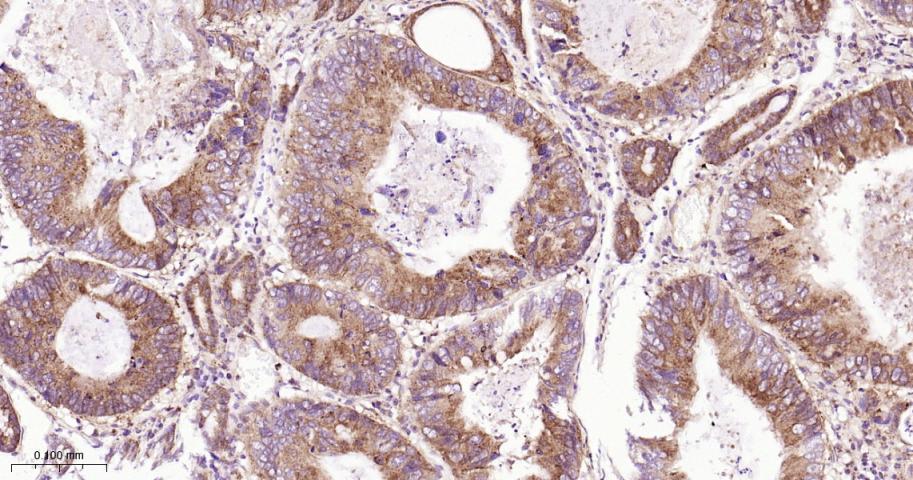
转铁蛋白受体（CD71）抗体
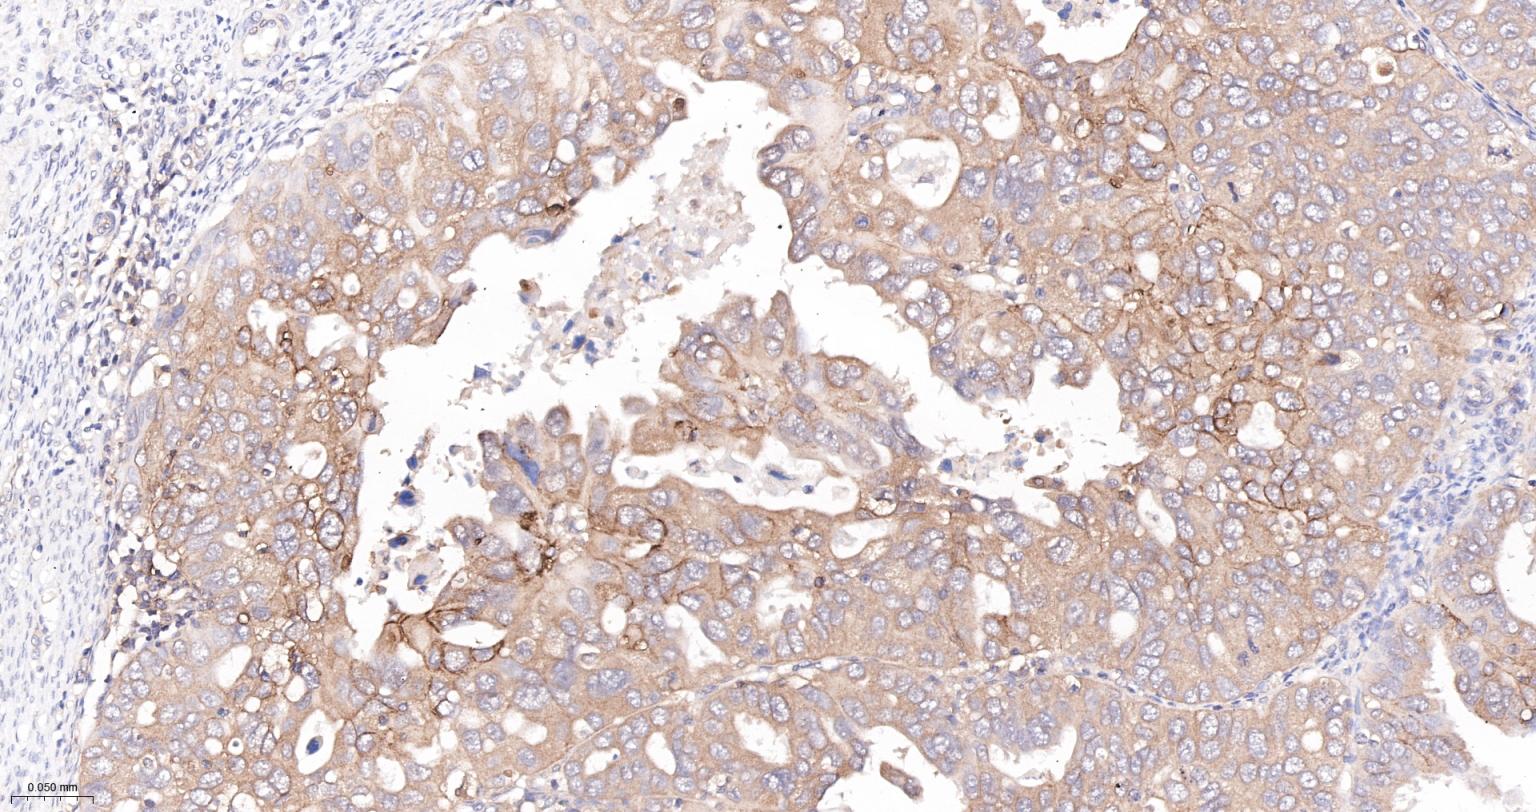
转铁蛋白受体（CD71）抗体

TFRC Recombinant Rabbit mAb (一抗) - WB,IHC-P,IHC-F,IF,Flow-Cyt | Bioss
Rrmab?兔单抗

货号:bsm-54633R
产品详情
相关标记
相关产品
相关文献
常见问题
概述
产品编号
bsm-54633R
产品类型
重组兔单抗、mIHC精品抗体
英文名称
TFRC Recombinant Rabbit mAb
中文名称
转铁蛋白受体(CD71)抗体
英文别名
CD71; IMD46; T9; TFR; TFR1; TR; TRFR; p90; 2610028K12Rik; E430033M20Rik; Mtvr1; TFR1_HUMAN; TFRC; TFR1_MOUSE; TFR1_RAT;
抗体来源
Rabbit
免疫原
KLH conjugated synthetic peptide derived from human TFRC
亚型
IgG
性状
Liquid
纯化方法
affinity purified by Protein A
克隆类型
Recombinant
克隆号
10H4
理论分子量
85 kDa
检测分子量
90 kDa
浓度
1mg/ml
储存液
1*TBS (pH7.4), 0.05% BSA, 40% Glycerol. Preservative: 0.02% Proclin300.
研究领域
Cancer > Cancer Metabolism > Response to hypoxia
Cardiovascular > Blood > Serum Proteins
Immunology > Cell Type Markers > CD > Non-lineage
Metabolism > Pathways and Processes > Metabolism processes > Hypoxia
Stem Cells > Hematopoietic Progenitors > Lymphoid > B Lymphocytic Lineage
Stem Cells > Hematopoietic Progenitors > Lymphoid > T Lymphocytic Lineage
Stem Cells > Hematopoietic Progenitors > Myeloid > Erythrocytic Lineage
SWISS
Gene ID
保存条件
Shipped at 4℃. Store at -20℃ for one year. Avoid repeated freeze/thaw cycles.
注意事项
This product as supplied is intended for research use only, not for use in human, therapeutic or diagnostic applications.
数据库链接
产品介绍
转铁蛋白及转铁蛋白受体(TfnrR)是机体铁代谢中的重要因子,铁是细胞生长增殖、代谢的必需元素,转铁蛋白受体(TfR)介导的胞吞作用是细胞摄取铁的主要途径。肿瘤细胞因增殖生长旺盛,对铁的需求高,所以肿瘤细胞有比正常细胞更多的转铁蛋白受体的表达。
背景资料
This gene encodes a cell surface receptor necessary for cellular iron uptake by the process of receptor-mediated endocytosis. This receptor is required for erythropoiesis and neurologic development. Multiple alternatively spliced variants have been identified. [provided by RefSeq, Sep 2015]

产品应用
| 应用 | 已检合格种属 | 预测种属 | 推荐稀释比例 |
|---|---|---|---|
| WB | Human | 1:500-1000 | |
| IHC-P | Human | 1:100-500 | |
| IHC-F | Human | 1:100-500 | |
| IF | Human | 1:100-500 | |
| Flow-Cyt | Human | 1:100-200 |
交叉反应
交叉反应: Human
相关产品
暂无相关产品
靶标
基因名
TFRC
蛋白名
Transferrin receptor protein 1
亚基
Homodimer; disulfide-linked. Binds one transferrin or HFE molecule per subunit. Binds the HLA class II histocompatibility antigen, DR1. Interacts with SH3BP3. Interacts with Machupo arenavirus GPC.
亚细胞定位
Cell membrane; Single-pass type II membrane protein. Melanosome. Note=Identified by mass spectrometry in melanosome fractions from stage I to stage IV.
翻译后修饰
N- and O-glycosylated, phosphorylated and palmitoylated. The serum form is only glycosylated.
Proteolytically cleaved on Arg-100 to produce the soluble serum form (sTfR).
Palmitoylated on both Cys-62 and Cys-67. Cys-62 seems to be the major site of palmitoylation.
Proteolytically cleaved on Arg-100 to produce the soluble serum form (sTfR).
Palmitoylated on both Cys-62 and Cys-67. Cys-62 seems to be the major site of palmitoylation.
相似性
Belongs to the peptidase M28 family. M28B subfamily.
Contains 1 PA (protease associated) domain.
Contains 1 PA (protease associated) domain.
功能
Cellular uptake of iron occurs via receptor-mediated endocytosis of ligand-occupied transferrin receptor into specialized endosomes. Endosomal acidification leads to iron release. The apotransferrin-receptor complex is then recycled to the cell surface with a return to neutral pH and the concomitant loss of affinity of apotransferrin for its receptor. Transferrin receptor is necessary for development of erythrocytes and the nervous system. A second ligand, the heditary hemochromatosis protein HFE, competes for binding with transferring for an overlapping C-terminal binding site.
同靶标产品
相关文献
提示: 发表研究结果有使用 bsm-54633R 时请让我们知道,以便我们可以引用参考文章。作为回馈,资料提供者将获得我们送上的小礼品。